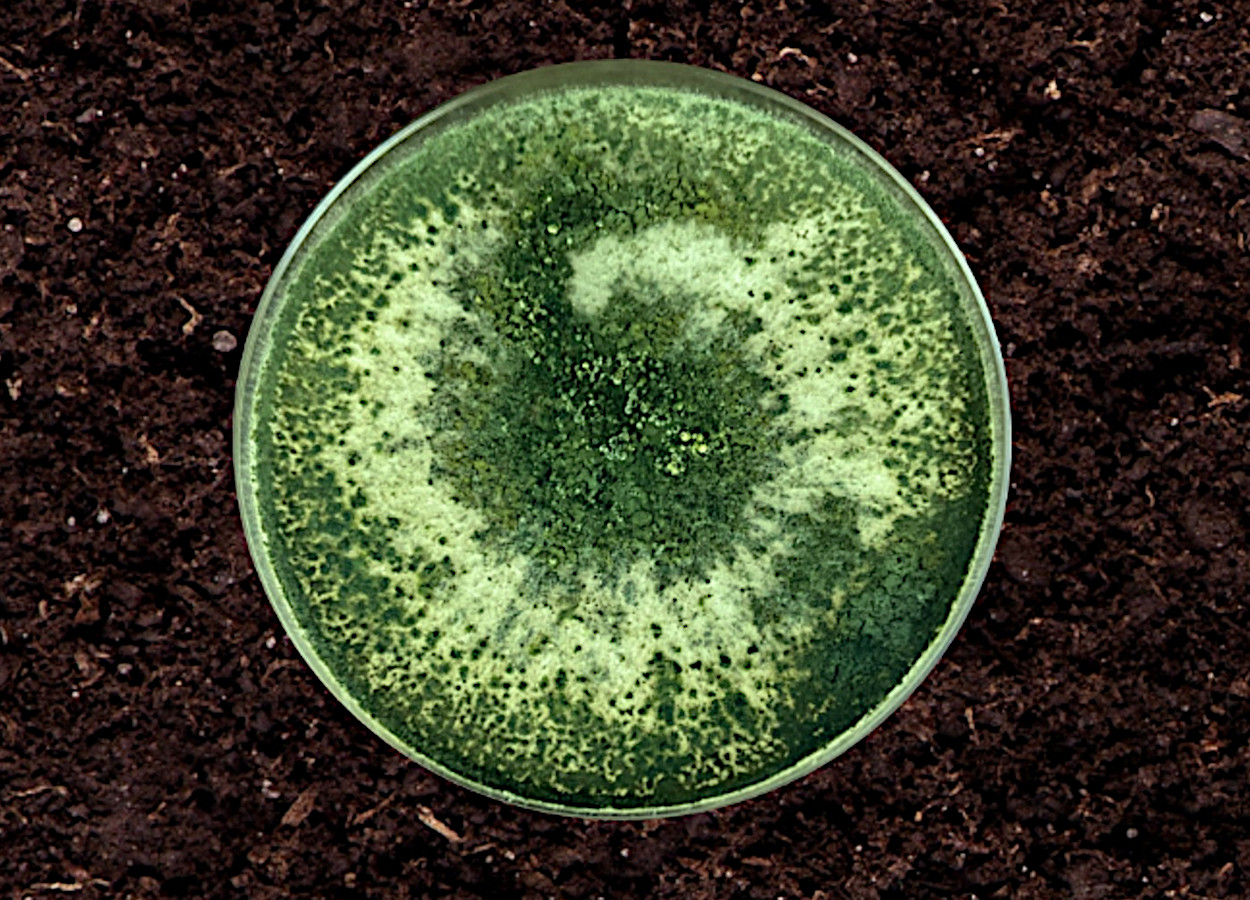

Inmet: previsão do tempo entre os dias 13 e 17 de outubro de 2025
Semana será marcada por contrastes climáticos, com chuvas no Sul e tempo seco no Nordeste
Foram pedidos os primeiros registros fungicidas à base do fungo Trichoderma yunnanense no Brasil. A ideia é usar os produtos contra Sclerotinia sclerotiorum, Rhizoctonia solani e Fusarium oxysporum.
Duas empresas iniciaram os procedimentos legais.
A Total Biotecnologia pediu dois. Usou nomes comerciais que devem ser alterados no futuro: DEF-MIC-052-23A e DEF-MIC-052-23A-1.
Já a Ihara pediu autorização para comercializar pesticida sob a marca Kouken, contendo Trichoderma yunnanense cepa IHA02.
Trichoderma yunnanense é uma das espécies mais promissoras para uso em manejo fitossanitário dentro do gênero Trichoderma. Tratam-se de fungos filamentosos amplamente reconhecido por suas capacidades antagonistas e promotoras de crescimento vegetal.
T. yunnanense, morfologicamente, apresenta micélio septado composto por hifas hialinas que crescem rapidamente e colonizam diversos substratos. Suas estruturas reprodutivas incluem conidióforos ramificados que produzem massivamente conídios assexuados, os principais propágulos de dispersão do fungo.
Seu ciclo de vida predominantemente assexuado permite rápida multiplicação e colonização oportunista de novos habitats. A germinação dos conídios ocorre em poucas horas sob condições favoráveis de umidade e temperatura, seguida pelo crescimento vegetativo extensivo e subsequente esporulação.
Com fungos patogênicos, T. yunnanense estabelece relações predominantemente antagônicas através de micoparasitismo, competição e antibiose. Isso resulta em supressão de populações de patógenos como Fusarium, Rhizoctonia, Pythium, Sclerotinia e Botrytis.

Receba por e-mail as últimas notícias sobre agricultura